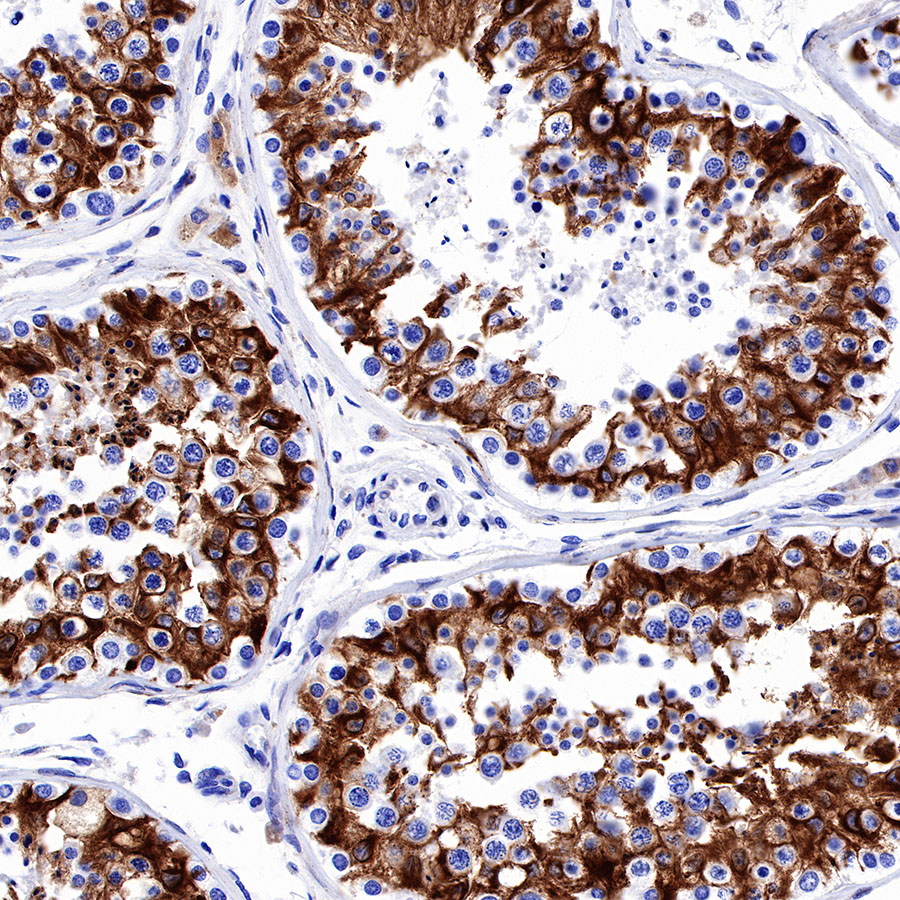

Product Details
Product Details
Product Specification
| Host | Rabbit |
| Antigen | SPARC |
| Synonyms | BM-40, Osteonectin, ON, Secreted protein acidic and rich in cysteine |
| Immunogen | N/A |
| Location | Secreted, Extracellular matrix, Basement membrane |
| Accession | P09486 |
| Clone Number | SDT-R136 |
| Application | WB, IHC-P, IP |
| Reactivity | Hu |
| Purification | Protein A |
| Concentration | 0.5 mg/ml |
| Physical Appearance | Liquid |
| Storage Buffer | PBS, 40% Glycerol, 0.05% BSA, 0.03% Proclin 300 |
| Stability & Storage | 12 months from date of receipt / reconstitution, -20 °C as supplied |
Dilution
| application | dilution | species |
| WB | 1:1000 | null |
| IHC-P | 1:2000 | null |
| IP | 1:50 | null |
Background
SPARC, also referred to as osteonectin or basement membrane protein 40 (BM-40), is a ~32 kDa calcium-binding matricellular protein [PMID: 22249026, PMID: 25064829]. At one time SPARC was thought to be expressed specifically in mineralized tissues (thus the name osteonectin) but was subsequently demonstrated to have a much wider expression pattern in both mineralized and non-mineralized tissues [PMID: 7034958]. Typically, expression of SPARC is closely aligned with that of fibrillar collagens such as collagen type I. The protein component of the pre-mineralized bone matrix (osteoid) is composed mainly of collagen type I (94%) and a number of noncollagenous proteins.
Picture
Picture
Western Blot

IP

SPARC Rabbit mAb at 1/50 dilution (1 µg) immunoprecipitating SPARC in 0.4 mg A375 whole cell lysate.
Western blot was performed on the immunoprecipitate using SPARC Rabbit mAb at 1/1000 dilution.
Secondary antibody (HRP) for IP was used at 1/400 dilution.
Lane 1: A375 whole cell lysate 20 µg (Input)
Lane 2: SPARC Rabbit mAb IP in A375 whole cell lysate
Lane 3: Rabbit monoclonal IgG IP in A375 whole cell lysate
Predicted MW: 35 kDa
Observed MW: 37 kDa
Immunohistochemistry